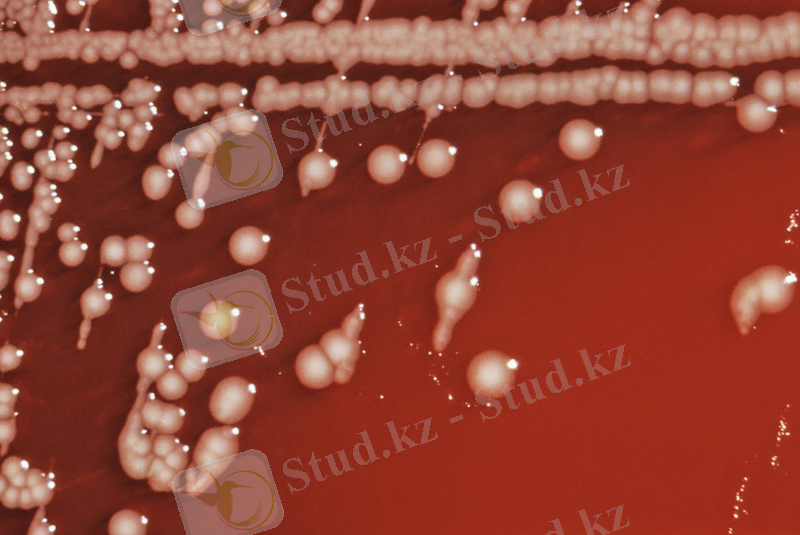
http://res.publicdomainfiles.com/pdf_view/58/13532019017298.jpg

Құстардағы сальмонеллез: клиникасы, диагностикасы және ветеринариялық-санитариялық сараптау


Кіріспе
Қазіргі уақытта қоздырғыштары бактериялар, вирустар мен қарапайымдар, сонымен қатар бактериялардың токсиндері (бұл жағдайда диареяны бактериялардың өздері емес, қоздырғыш көбейген тағам өнімдерімен ас қорыту жолына түскен токсиндер тудырады) болатын 30-дан аса нозологиялық формалар белгілі.
Сальмонеллез ауруы жануарлар мен адамдар арасында болатын жіті ішек ауруы, көп жағдайларда азық-түлік арқылы беріліп, асқазан-ішек жолдарының зақымдалуымен сипатталатын бактерия тудыратын ауру. Біздің облыста жыл сайын 150-ден 200-ге дейін оқиғалар тіркеледі. Бүкіл әлемде 10 миллиондаған адам ауырып, жүз мыңдаған адам өлімге ұшырап жатыр. Қазіргі күнде Salmonella бактерияларының 2500-ден астам штамдары кездеседі [1] .
Сальмонеллездер, оның ішінде, сальмонеллезді гастероэнтериттер бүкіл әлемде көптеп тараған; олар адамдардан басқа сүтқоректілерде, құстарда, қосмекенділерде де кездеседі. Бұл аурумен үй жануарлардың ауыруы ауыр экономикалық шығын әкеледі. АҚШ тұрғындары арасында 1 жылдың ішінде сальмонеллезбен ауырған 2 млн. астам адам тіркелген.
АҚШ-да сальмонеллез ауруынан шыққан экономикалық шығын - 2 млрд. долларға бағаланып отыр, ал Канадада -300 млн. ТМД елдерінде соңғы 15 жылда адамдар мен құстар сальмонеллезі 7 есеге көбейіп отыр, оның ішінде этиологиясы S. Enteritidis болатын адам ауруы 30%, құстардыкі - 75% өсіп отыр. Азық-түлік өнімдерінде қоздырғыштардың болуы - 50%-ға өскен. Сондықтан Қазақстан Республикасының жоғары білімді мамандарының міндеттері мен мақсатары ол қандайда болмасын ауыл шаруашылық салаларында жұмыс атқарғанда малдәрігерлік ісін ұйымдастыру жұмыстарын дұрыс жоспарлау, малдардың өсуін, құнын жоғарлату қандай да болмасын аурудан сақтау болып табылады [1, 2] .
Курыстық жұмыстың мақсаты: Құстардың сальмонеллез ауруы кезіндегі ветеринарлық-санитарлық сараптауды игеруі
Курстық жұмыстың міндеттері:
- Құс ұщаларын ашып сою, оларды органолептикалық және физико-химиялық зерттеулерден өткізу;
- Құстардың ет сынамаларын микробиолгиялық зерттеулерден өткізу.
1. Әдебиетке шолу
1. 1 Сальмонеллез ауруының сипаттамасы және таралуы
Сальмонеллез - жіті өтетін зардапты ауру, ішекқарын жолының, бауырдың зақымдануымен, көкбауырдың үлкеюімен және дене қызуының көтерілуімен сипатталады.
Сальмонеллезбен барлық ауылшаруашылық, үй, кәсіптік, жабайы, зертханалық жануарлар мен құстардың барлық түрі ауырады, әсіресе жас мал сезімтал. Ауру қоздырушысы Enterobacterіceae тұқымдасының Salmonella түріне жататын бактериялар. Сальмонеллез - бактериалды жұқпалы ауру, көбінесе ішек - қарын жолдарына зиян келтіреді, бұл жануарлар мен адамдар арасында болатын жіті ішек ауруы, көп жағдайларда азық-түлік арқылы беріліп, асқазан-ішек жолдарының зақымдануы арқылы сипатталатын жұқпалы ішек ауруы. Ауру қоздырғышы сальмонелла болып саналады. Ол көптеген аңдар және құстар ағзасында мекендейді. Сальмонеллалар суыққа төзімді және ұзақ қайнатқанда ғана жойылады.
Сүтте, тартылған етте, жұмыртқа ұнтағында, сальмонеллалар өмірге бейімділігін сақтай отырып, көбеюі де мүмкін. Сальмонеллез жұқпасының бактериялары төмен температурада ғана өмірге бейімді. Бірақ 50°С-тен 100°С аралығында жойылады.
Инфекцияның негізгі көзі - ауыл шаруашылық жануарлары мен құстар, сальмонеллезбен ауру адамдар және бактерия тасымалдаушылар болып табылады.
Инфекцияны тасымалдайтын негізгі факторларға әртүрлі тағам өнімдері ( мал, құс еттері, балық, устрица, теңіз шаяны, жұмыртқа және жұмыртқа ұнтағы, сүт және сүт тағамдары), көкөністер мен жемістер, кремді өнімдер жатады. Су ауруды жиі тасымалдаушы факторлардың бірі болуы мүмкін [3] .
Таралу жолдары: Ауру қоздырғышы адам ағзасына сальмонеллез жұқтырылған және дұрыс термикалық өңделмеген тамақ өнімдерін пайдаланған кезде түседі (ет, сүт өнімдері, жұмыртқа) . Сальмонеллезбен 10 күннен бір айлыққа дейінгі бұзаулар ауырады. Алғашында әлсіз, жетілмеген бұзаулар ауырады. Қоздырғыштың уыттылығы ұлғайғанда дені сау малдар ауыра бастайды. Жұғудың алғашқы жолы әдетте індеттелген сүт арқылы жұғады. Желіндегі сүтте сальмонеллез бактериялары болмайды, бірақ та сиырларды лас жерде сауу процессінде аздаған кепкен нәжіс бөлігі сүтке түседі, сиыр нәжісінде - сальмонеллез тасымалдаушылар сальмонеллез құрамында жиі болады. Егер бұзауға сүтті сауғаннан кейін бермесе, мұндай сүттер өте қауіпті, өйткені сүт сальмонелла үшін жақсы қоректік орта болып табылады. Оның күшею қауіптігі сальмонеллалар сүтті ашытпайды және түсін өзгертпейді. Аурудың бірінші жағдайынан кейін, індеттің негізгі суыққоймасы болып ауру бұзаулар, нәжіспен, зәрмен және басқа нәжістермен барлық қоршаған ортаны індеттейді [4] .
1. 2 Сальмонеллез ауруының клиникалық белгілері және өлген жануарда болатын патологиялық-анатомиялық өзгерістер
Сальмонеллездің жіті формасы кезінде ауру 5 - 10 күнге созылады. Одан әрі үш нәтиже мүмкін: өлім, жайлап жазылу немесе созылмалы формаға ауысуы. Жазылуы жайлап, аптаға созылады. Ауырып жазылған бұзаулар өсуінен тоқтап және қораш болып көрінеді. Созылмалы түрінде ауру апта бойы және айларға созылады. Созылмалы формасының негізгі белгілері өкпенің қабынуы болып табылады.
Ауру 40 - 41 0 С одан да жоғарғы температурамен басталады. Қызба күнделікті және аурудың аяғына дейін тұрады. Температурамен қатар пульс та (бір минутта 110 - 150 дейін) және тынысы да (60 - 80 дейін) жиілейді. Сирек жағдайда ауру басталғанда бронхитбайқалады:везикулярлы тыныс алу жөтел ұлғайады, құрғақ саңғырлаған қырыл болады. Аурудың бірінші күні серозды конъюнктивит және жас ағулар пайда болады. Тәбеті құбылмалы болады. Бұзау біресе сүт нормасын жақсы ішеді, не бас тартады. Нәжіс сұйылады, құрамында клегейлі, қанды қоспалар болады. Ауыр жағдайда температурасы жоғарғы сатыда болады.
Мал қатты әлсірейді, басын жерге түсіріп, созып жата береді. Күшінің қатты төмендеуінен, депрессиядан, жүрек қызметінің әлсіреуінен бұзау 5 - 10 күні өледі. Егер аурудың жеңіл жағдайында аздап жазылады немесе созылмалы формаға ауысыды [5] .
Патологоанатомиялық белгілер: Маңызды өзгерістер құрсақ қуыс мүшелерінде кездеседі. Әсіресе талақ қатты өзгереді, ол күрт ұлғайған және салмағы 2 - 3 есе артады. Талақ түсі қошқыл - қызыл, шеттері дөңгелектенген, капсуласы шиеленіскен, оның астында буындар байқалады және дақты, нүктелі қанталаулар кездеседі. Ішектің клегей қабықтары, кейде ұлтабар қабынған, қызарған, қан талаулар кездеседі. Шажырқай лимфа түйіндер домбыққан, ісінген, ұлғайған. Бауыр көбінесе нормадан тыс немесе паренхиматозды дегенерация жағдайында. Анда - санда бауырда, сонымен қатар талақта ұсақ, дән секілді, сарғыш - сұр түсті некроз ошақтар болады. Бұл түйіндер сальмонеллезге тән, бірақ та олар сирек кездеседі. Осыған байланысты бауыр немесе талақты кескен кезде лупаның көмегімен қарау қажет. Бүйректердегі өзгерістер капсула астында қан талаулар болады. Зәр қабы зәрге толған. Оның клегей қабығы домбыққан, гиперемияланған, қан талаған. Көкірек қуыс мүшелерінде қан талаудан басқа жүрек бұлшықеттерінің дегенерациясын байқауға болады: ол болбыр, кескіні бұлдыр. Пневмония жіті жағдайда дамып үлгермейді [6] .
1. 3 Қоздырушылардың морфологиясы және биологиясы, оны анықтау тәсілдері
Қазіргі мәліметтер бойынша Salmonella туысының құрамына сальмонелланың 2 түрі кіреді: Salmonellaenteritica (6 түршесі) және Salmonellabongori .
Антигендік құрлымы бойынша сальмонелла сероварларының 2400 түрін ажыратады, көбісі Salmonellaenteritica (ертерек S. choleraesuis) түршесіне жатады. Малдардың ауруына үлкен мағыналар білдіреді S. enteritidis (dublin), S. choleraesuis, S. typhisuis, S. typhimurium, S. abortusequi, S. abortusovis, S. pullorum (gallinarum) [7, 8] .

Сурет 1. Salmonella enteritica таяқшаларының көрінісі
Salmonella тобының бактериялары морфологиялық жағынан, боялу қатынасы бойынша, өсу өзгешелігі және ЕПА, ЕПС, ЕПЖ және басқа да қарапайым қоректік орталары өзара өте ұқсас болып келеді. Факультативті аэробтар спора және капсула түзбейді. Осы топтың көптеген өкілдері (S. gallinarum басқа) қозғалғыш. Грам теріс, сүт ұйымайды (қыздырған кезде де) . Осы топтың кейбір өкілдері тығыз орталарда (қарапайым және түрлі түсті агар) 37°С 24 - сағат бөлме температурасында 2 - 4 тәулікте өсірген кезде тізбектің айналасында клегейлі үймек түзеді. Үймек түзу көптеген штамдарға тән. Е. coli топ өкілдерімен салыстырғанда көмірсулар мен көп атомды спирттер қатынасы бойынша аздап белсенді. Лактоза мен сахарозаны ыдыратпайды. Күкіртті сутек түзіледі, бірақ та барлық түрлерінде емес, индол түзбейді [9] .
Сальмонеллез қоздырушыларының түрлерін бір - бірінен, сонымен қатар ішек таяқша топ өкілдерінен ажырату арнайы қоректік орталар мен серологияның көмегімен жүргізіледі. Көмірсулар мен көп атомды спирттер ортасында және Андредэ индикаторымен (бромтимолблау және т. б. ) микроб өскенде газ түзілуі і және қышқыл түзілгенде қызғылттан қызылға дейін орта түстері өзгереді. Штерна сорпасы оң нәтиже бергенде (глицерин ыдырағанда) пурпур түсті белсенді қабылдайды; орта қызғылт түске боялса ол оң сынамаға саналмайды. Биттер ортасы рамнозамен 15 - 20 сағат аралығында егіп өсіргеннен кейін термостатта қышқылдығына 2 - 3 тамшы индикатор - метилрот (0, 5% спирт ертіндісі) қосылып сыналады. Егер ортаның рН 5, 0 төмен болса қызыл түске (мысалы, S. typhimurium), егер жоғары болса сары түске боялады (мысалы, S. enteritidis) . Salmonella топ өкілдерінің дифференциалды түрлі - түсті орталары (Эндо, Левин орталары және бактоагарда Ж мөлдір тізбектер, түссіз, Дригальский - көк, бромкрезолды ортада-ашық - көк, Гасснер- сарғыш) өзгермейді. Строговтың синтетикалық ортасында сальмонеллалар өспейді, Е. coli қарағанда [10] .
Сурет 2. Salmonella choleraesuis колонияларының ЕПА-дағы өскен шоғырлары
Сальмонелла мен ішек таяқшаларын ажырату тестілері
Ескерту:
К - қышқылдың түзілуі; КГ - қышқыл мен газдың түзілуі

Сурет 3. Salmonella typhimurium таяқшалары
1. 4 Салмонеллез ауруы бойынша ветеринариялық іс-шаралар жүргізу тәртібі
Ветеринариялық-санитариялық қолайлы аумақтарда жүзеге асырылатын салмонеллездің профилактикасы бойынша жүргізілетін ветеринариялық іс-шаралар тәртібі.
Жануарлар мен құстардың арасында салмонеллездiң таралуын болдырмауға бағытталған негізгі іс-шаралар:
- шаруашылық жүргізуші субъектілерде жаңа туған жануарлардың және өсіріліп жатқан төлдердің ағзасының резистенттілігін көтеруге бағытталған санитарлық-ветеринарлық тәртіптің сақталуын қатаң бақылауды жүзеге асыру;
- ауру жануарлар мен инфекция тасымалдағыштарды уақтылы анықтау жөнінде жануарлар мен құстардың ауруына қатаң ветеринариялық-санитариялық бақылауды және қадағалауды орнату;
- жануарларға арналған өндірістік қора-жайларды дезинфекциялау мен дератизациялау жүргізу;
- шаруашылық жүргізуші субъектілерді қолайлы шаруашылық жүргізуші субъектілерден ғана жануарлармен толықтыру;
- ветеринариялық-санитариялық бақылауды және жануарлар тасымалдаудың ветеринариялық-санитариялық (ветеринариялық) қағидаларының сақталуын қадағалауды жүзеге асыру;
- рационды бірден өзгертуге, бұзылған азық беруге, сапасыз сумен суаруға жол бермеу;
- азық пен азық қоспаларына ұдайы Сальмонеллалармен ластануға бактериологиялық бақылау жүргізу [11] .
Жануарларды сою өнімдерінде көбейетін сальмонеллаларды шығаруды болдырмау мақсатында мыналарды жүргізеді:
1) мал сою объектілерінде (ет өңдейтін кәсіпорындарда, мал сою пункттері мен алаңдарында) санитарлық мәдениетті арттыруға, сояр алдында ұстау режимін сақтауға және жануардан алынатын шартты түрде жарамды өнімді залалсыздандыруға бағытталған іс-шараларды;
2) шаруашылық жүргізуші субъектінің салмонеллез бойынша қолайлы екендігі туралы белгісі бар келіп түскен малдардың құжаттамаларды және ұшаны, басты, өкпе-бауырды, теріні бірыңғай нөмірмен таңбалауды;
3) қалдықтарды дұрыс жинақтауды, зарарсыздандыруды және жоюды жүргізеді.
Сүт шаруашылығын жүргізуші субъектілерде сүттi жинау, сақтау және тасымалдаудың санитарлық шарттарын қатаң түрде орындау, сүт ыдыстарын, мүкәммалын, жабдықтарын сапалы санитарлық өңдеуді қамтамасыз етеді [12, 13, 14, 15, 16] .
Салмонеллез бойынша қолайсыз пункттерде жүргізілетін ветеринариялық іс-шаралар тәртібі.
Салмонеллез анықталған кезде шаруашылық жүргізуші субъектіге шектеулер қойлады. Шектеу шарты бойынша мыналарға жол берілмейді:
1) жануарларды және құстарды басқа шаруашылық жүргізуші субъектіге әкелуге және шығаруға;
2) шаруашылық жүргізуші субъекті iшiнде жануарларды және құстарды қайта топтастыруға;
3) шарасыздан сойылған жануарлар мен құстардың етiн алдын ала бактериологиялық зерттеуге жүргізбестен, ал егер зерттеу мүмкін болмаған жағдайда - жоғары температурада залалсыздандырмай пайдалануға;
4) шаруашылық жүргізуші субъектінің басқа секцияларындағы адамдардың, сондай-ақ бөгде адамдардың арнайы киiмсiз және аяқ киімдерін дезинфекцияламай оқшаулағышқа кiруiне;
5) салмонеллез бойынша қолайсыз шаруашылық жүргізуші субъектінің жайылымдарына жануарларды жаюға және азық дайындауға;
6) қолайсыз құс қорасындағы құстарды, құстардың инкубациялық жұмыртқасын шығаруға жол берілмейді [17, 18, 19, 20] .
Шаруашылық жүргізуші субъектіде салмонеллез өршіген уақытта жануарларды міндетті түрде термометрлей отырып бас басына клиникалық тексереді. Ауру және ауруы күдiктi жануарларды оқшаулайды және емдейді.
Сальмонеллезбен ауырған жануарлар және құстар табылған қора-жайларда, сондай-ақ торларда, науаларда, өтетін жерлерде, инкубаторларда, қосалқы қора-жайларда және жайылымдарда дезинфекция, дезинвазия, дезинсекция және дератизация бойынша ветеринариялық-санитариялық іс-шаралар жүргiзедi.
Шаруашылық жүргізуші субъектіні ауруды жойғаннан, қорытынды дезинфекция жасағаннан және аурудан сауыққан жануарларды союға өткізгеннен кейін күнтізбелік 30 күн өткен соң жануарлардың салмонеллезі бойынша қолайлы деп таниды [21] .
2. Өзіндік зерттеулер
2. 1 Материалдар мен зерттеу әдістері
Осы курстық жұмыс Қостанай облыстық ветеринарлық зертханасының азық-түлік қауіпсіздігі зертханасында және А. Байтұрсынов атындағы Қостанай аймақтық универсиетінің ветеринариялық санитария кафедрасында жүзеге асырылды. Курстық жұмыс жазу барысында, сальмонеллез ауруы анықталып, лажсыздан сойылған 10 тауық ұшасы зертханаға түсті. Ол ұшаларды ашып-сойып, органолептикалық, физико-химиялық және микробиологиялық зерттеулерден өткіздік. Зерттеу нәтежиелерін белгіленген кестелерге енгізіп, рәсімдедік.
Сойылған құс етінің ұшасын сараптағанда сырты мен ішкі мүшелері қаралады. Ветеринариялық сантариялық сараптау үшін ұшаларды қарайтын жұмыскер дайындайды.

Сурет 4. Сальмонеллезден өлген тауықтар
Ұшаны толық ішек-қарнынан тазарту үшін жұмыскер конвейрге ілініп тұрған ұшаның құрсақ қуысы арқылы ішек қарнын, асқазан, бауыр, жүрек, талақты тартып алып, ұшаның сол жағында қалдырады, немесе бұл жұмысты машина - ішек-қарнын тазартын автомат жасайды.
Құсты толық жарып сою ұшаның ветеринариялық санитариялық сарапталуын, жоғары сапалы өнімнің шығарылуын, эпидемиологиялық және эпизоотологиялық жағдайыдын жақсы болуын қамтамасыз етеді. Ұшаны жартылай ішек-қарнынан тазарту бұндай талаптарды орындай алмайды, себебі аналық ұшалардың ішкі мүшелерінің ішіндегі жұмыртқа бездері қаралмай ветеринариялық сараптамадан өтпейді.
Құсты жартылай ішек-қарнынан тазартқанда көптеген жұқпалы аурулар құс ұшасында байқалмайды, мысалы колисептицемия, туберкулез, сальмонеллез, орнитоз, туляремия, листериоз, стрептококкоз, лейкоз және тағы басқа аурулар сауда орындары мен қоғамдық тамақтану орындарына түсуі мүмкін.
Ұшаны жартылай ішек-қарнынан тазартқанда құрсақ қуысы бойында кішкентай кесінді жасайды, сол арқылы сыртқа ішектер мен жүмыртқа бездері шығады. Басқа ішкі мүшелері: жүрек, бауыр, талақ, бүйрек жұқпалы және жұқпалы емес ауруларда жиі зақымдалады, ал ветеринариялық санитариялық сараптаушы үшін кеуде-құрсақ қуысындағы және ілініп тұрған асқазан мен жұмыртқа бездері жасырын болып қалады.
Ішкі мүшелерінің созылмалы түрде зақымдалуы сальмонеллезбен, туберкулезбен, лейкозбен, стрептококкозбен және тағы басқа аурулармен ауырғанда байқалады. Іріңді түйіндер, бұршақ дәніндей көлемдегі туберкулдер, фибринозды-геморрагиялық ошақтар, қанталаулар және т. б., кейде бұл мүшелер болбыр және оларды ұстағанда жыртылуы мүмкін. Бұндай мүшелерде көп мөлшерде токсиндер, әртүрлі патогенді, шартты патогенді және сапрофитті микрофлора болады.
Жартылай жарып сою кезінде алынбаған ошақтар дені сау құста токсикоинфекция, интоксикация және адамдарда улану тудыруы мүмкін. Өкпе, бауыр, бүйрек және безді және бұлшық етті асқазан, ішектерде әртүрлі микрофлора болады, сонымен қатар сальмонеллалар, клостридиялар, кокктар және т. б., олар айналасындағы ұлпаларға еніп - бұлшық ет, оларда көбейіп, токсин жинауы мүмкін, сондықтан бұндай етті қабылдаған адамдар арасында уланулар тудыруы мүмкін.
Бұның бәрінен сақтануға болады, егер құсты толық ішек-қарнынан тазартып шығарса.
Ветеринариялық дәрігердің жұмыс орнын бөлшектеу учаскесінде немесе жартылай бөлшектеу жерінде орналастырады.
Ветеринариялық санитариялық жұмыскерлердің еңбегін ұйымдастыру конвейрдің қозғалу жылдамдығы мен өңделген құстың жақсы болуына байланысты. 1 сағат ішінде 500-1000 бас құсты өңдегенде бір ветеринариялық дәрігер және бір көмекші болғанда жақсы сарапталады, олардың міндеттеріне күмәнді немесе күдікті ұшаларды өлшеу және дәрігер анықтаған патологанатомиялық өзгерістері бар мүшелерді жазып алу кіреді. Егер де 2000 басты өңдеген кезде сараптауды екі дәрігер және бір көмекші жүргізсе, ал 3000 басты өңдегенде үш дәрігер және екі көмекші атқарады.
Жұмыс үрдісі кезінде ветеринариялық санитариялық дәрігерлер орындарымен ауысып отыруы керек (бір дәрігер ұшаларды қараумен айналысса, екіншісі конвейерден түскен ұшаларға қарау жүргізеді), ондай тәртіп шаршап-шалдығудың болдырмай, сараптаудың, сонымен қатар құсты қабылдау, алдын ала қарау, цехтің санитариялық жағдайын бақылау, құсты технологиялық өңдеу, сақтау және өнімді жіберу жұмыстарының сапалы болуын қамтамасыз етеді.
Ветеринариялық санитариялық сараптау келесі тәртіппен орындалады: алдымен ұшаның тері беткейі, көзге көрінетін кілегей қабықтар қаралады, қансыздану дәрежесін анықтайды, кейіннен басты, мойынды, ішкі мүшелерді, кейде құрсақ қуысын қарайды.
Ұшаны сыртқы қарау кезінде союдың дұрыстығына, қансыздану дәрежесіне, өңдеуіне, тері мен буындардағы патологиялық өзгерістердің (ісіктер, жарақат, эррозиялар, тазқотыр және т. б. ) бар-жоғына назар аударады.
Дені сау құс ұшасының қансыздану дәрежесі қанағаттанарлық болса терісі ақ немесе ақшыл қызыл реңді, сары түсті көк дақтарсыз болады. Терінің қызыл түсті болуы, қанат астында, кеуде, шапта қантамырлар толық болуы құстың нашар қансызданғанын білдіреді. Ондайда бауыздаған жерінен қан немесе қан тәріздес сұйықтық ағады.
Бас пен мойынды қарау кезінде айдарына, сырғасына, синустарына, тұмсығына, ауыз қуысына және көзіне назар аударады. Бас пен мойынның, айдары мен сырғаларының терілерінің түсін ажыратады. Тұмсығын қараған кезде оның түсіне, жылтырлығына, құрғақтығына, серпімділігіне көңіл бөледі. Ауыз қуысында ауыздың кілегей қабығының жағдайына, тіліне, жұтқыншағына (түсі, иісі, кілегейі, түйіндер, пленкалар, казеозды пробкалар) назар аударады. Көзді қараған кезде көздің қасаң қабығының жағдайын: мөлдірлігі, тасырайғанын, көз алмасының мөлшерін, кілегейдің бар-жоғына, ісінуін анықтайды. Өңеш пен асқазанды кесіп қарайды, ал инфекциялық ауруларға күмән туған жағдайда трахеяны да кесіп қарайды.
Бас пен мойынды сыртқы қарау кезінде шешек, дифтерит, оба, тырысқақ, қылау, ларинготрахеит, конъюктевит, тазқотыр және тағы басқа инфекциялық аурулар белгілерінің бар жоғын анықтайды.
... жалғасы- Іс жүргізу
- Автоматтандыру, Техника
- Алғашқы әскери дайындық
- Астрономия
- Ауыл шаруашылығы
- Банк ісі
- Бизнесті бағалау
- Биология
- Бухгалтерлік іс
- Валеология
- Ветеринария
- География
- Геология, Геофизика, Геодезия
- Дін
- Ет, сүт, шарап өнімдері
- Жалпы тарих
- Жер кадастрі, Жылжымайтын мүлік
- Журналистика
- Информатика
- Кеден ісі
- Маркетинг
- Математика, Геометрия
- Медицина
- Мемлекеттік басқару
- Менеджмент
- Мұнай, Газ
- Мұрағат ісі
- Мәдениеттану
- ОБЖ (Основы безопасности жизнедеятельности)
- Педагогика
- Полиграфия
- Психология
- Салық
- Саясаттану
- Сақтандыру
- Сертификаттау, стандарттау
- Социология, Демография
- Спорт
- Статистика
- Тілтану, Филология
- Тарихи тұлғалар
- Тау-кен ісі
- Транспорт
- Туризм
- Физика
- Философия
- Халықаралық қатынастар
- Химия
- Экология, Қоршаған ортаны қорғау
- Экономика
- Экономикалық география
- Электротехника
- Қазақстан тарихы
- Қаржы
- Құрылыс
- Құқық, Криминалистика
- Әдебиет
- Өнер, музыка
- Өнеркәсіп, Өндіріс
Қазақ тілінде жазылған рефераттар, курстық жұмыстар, дипломдық жұмыстар бойынша біздің қор #1 болып табылады.



Ақпарат
Қосымша
Email: info@stud.kz